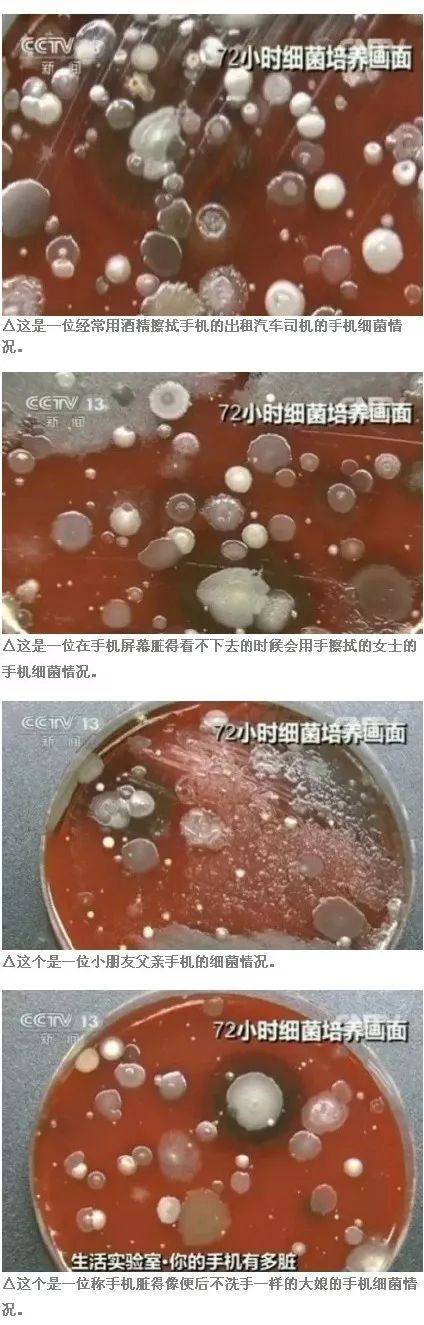
图片来源@央视新闻

手机屏幕有多脏,你可能无法想象……每天N次摩擦的指纹、水渍,还有各种灰尘,更别说是把手机放在包包、口袋里面之后,沾染上的其他污渍灰尘了。
央视曾经针对触屏智能手机做过一个实验,检测触屏手机的表面细菌含量。虽然这个新闻已经很久了,但是看到还是会很震惊。

我们的手机在使用状态下保持的温度最适宜细菌滋生,专家的72小时细菌实验结果表明:
正常使用的手机屏幕细菌高达26万个,比厕所的马桶还脏10倍!
图片来源@央视新闻
我看看右手握着的手机,再看看左手捏着的大馍,心情很复杂。怎么办?难道要戒掉手机?
不用担心!今天就给大家安利一款来自丹麦的屏幕清洁神器——AM mist!

这款由丹麦AM公司设计的屏幕清洁喷雾,把北欧简约精神进行到底,什么突出的喷嘴啊、瓶盖啊,通通out!
iPhone、iPad、iPod、平板电脑、笔记本电脑、相机屏幕、电视、手持控制台、Kindle,各种电子屏幕统统可以清洗,还可以杀菌!
它最大的亮点是——清洁布和喷雾是一体化,喷完就擦,不用找抹布找半天,也不用烦恼擦完该怎么收纳。那清洁布用久了脏怎么办呢?直接拿出来机洗就行啦。
喷一次,除菌效果可以保持24小时。
瓶身和一管口红那么大,丢在包里不占位,五种颜色都美得不要不要的。从此每天都可以用新手机啦。

强大的超细纤维布,能让所有屏幕一擦即不留下任何痕迹,还有厉害的中性清洁剂可以搭配,不含任何化学腐蚀物质也不含酒精,呵护你的双手却能除去屏幕上99.9% 的细菌。

AM屏幕清洁器采用美国进口原液,无刺激气味,无毒害,对宠物和儿童安全。无醇无氨配方,杜绝刺激慈宁宫化学物质,安全清洁。

喷雾小方瓶很方便就能从拭布外壳里取出,内含10.5毫升清洁液,可以供至少120次清洁次数。
使用完,可以换新的套装或购买清洁液添加进去。

一方面,丹麦总部的AM实验室专注于改良功能的独家配方清洁液;
另一方面,AM与美国纽约知名的设计公司Aruliden合作,对产品的外型进行多次重塑。并获得了多项国际设计大奖!

多数细菌,灰尘,污渍是看不到的,AM不仅创造快乐独特理念的清洁产品,更准备掀起全民的数码清洁热潮,享受更有趣,更丰富,更便捷的清洁体验!

一起看看AM mist的视频
这小东西又美又实用又便宜又环保,我每天都会用它擦手机和电脑屏幕,简直完美。




